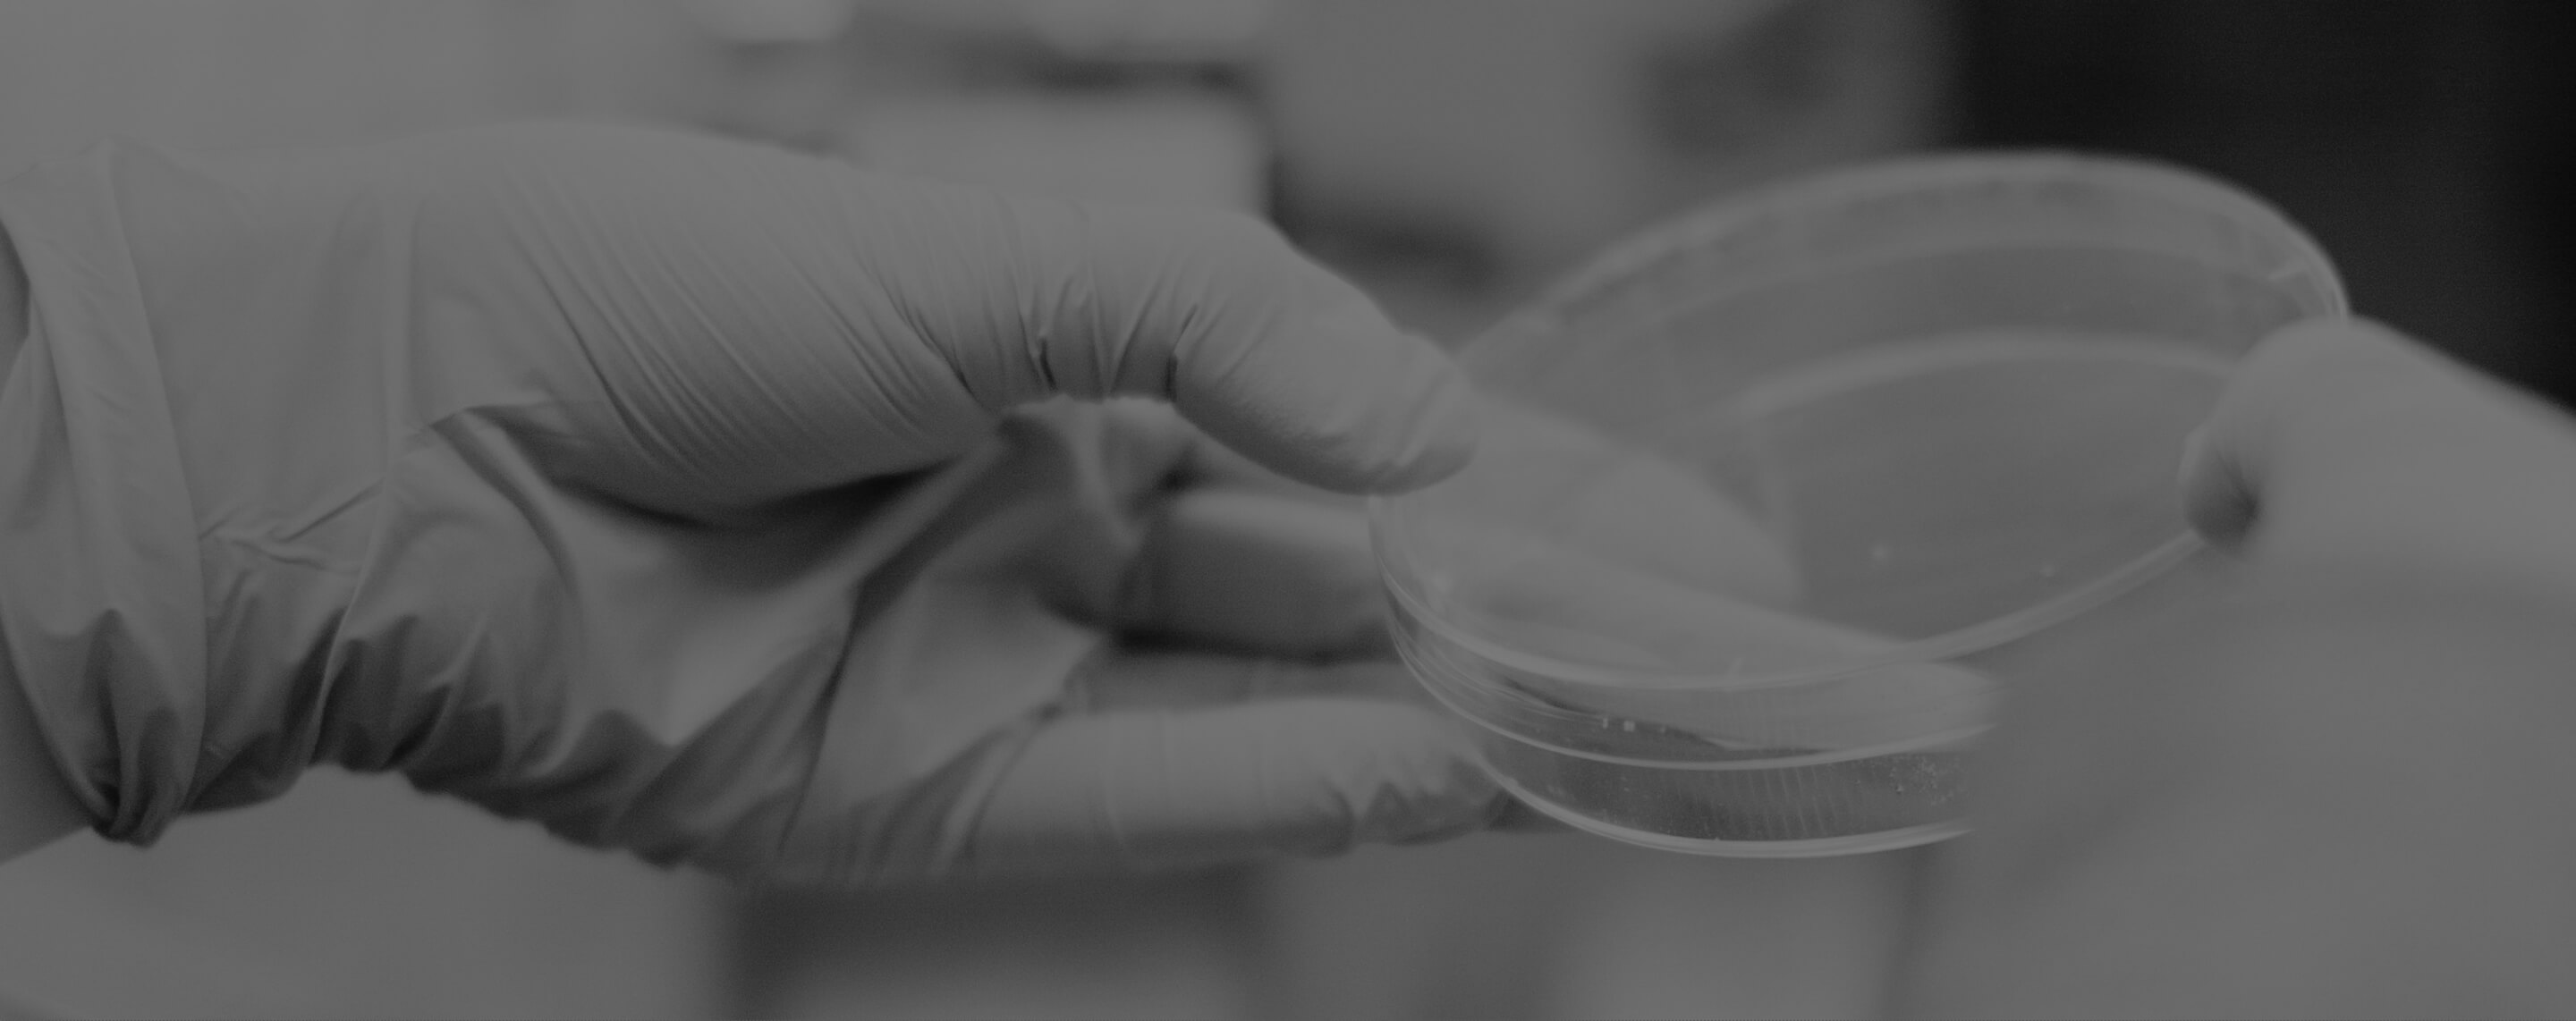

04
Proof
We're working with numerous companies at the forefront of biology, including three Fortune 500 companies. Learn about the future today.
50+
Compounds tested
170+
Unique patient backgrounds modeled
87%
Concordance with human outcomes
1 Phase 1 trial informed by our data
10x
Faster than traditional drug discovery
1000x
Lower costs
0
Animals killed
05
What we do
Introducing human-first drug discovery


01
/
03
Drug discovery
We’ve re-written the entire process of drug discovery, using our map of human biology to go from disease target discovery to IND in a fraction of the time and cost

02
/
03
Precision medicine
Accurate maps of human biology unlock personalized insights and patient stratification in ways never previously possible

03
/
03
Foundation models
Our closed loop, end-to-end automation is an engine of continuous data generation, creating a flywheel to build one of the largest sets of human biological data - with endless potential